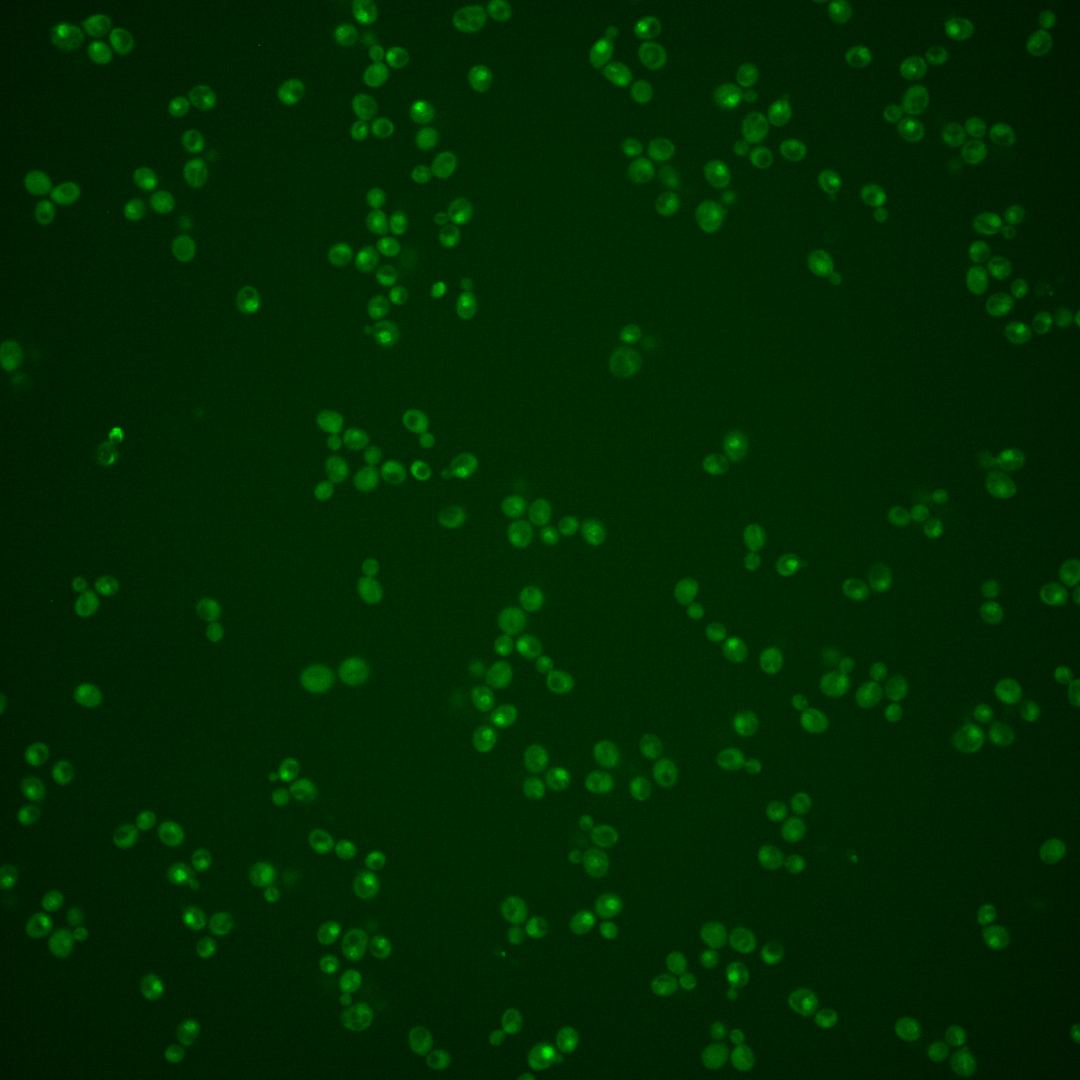
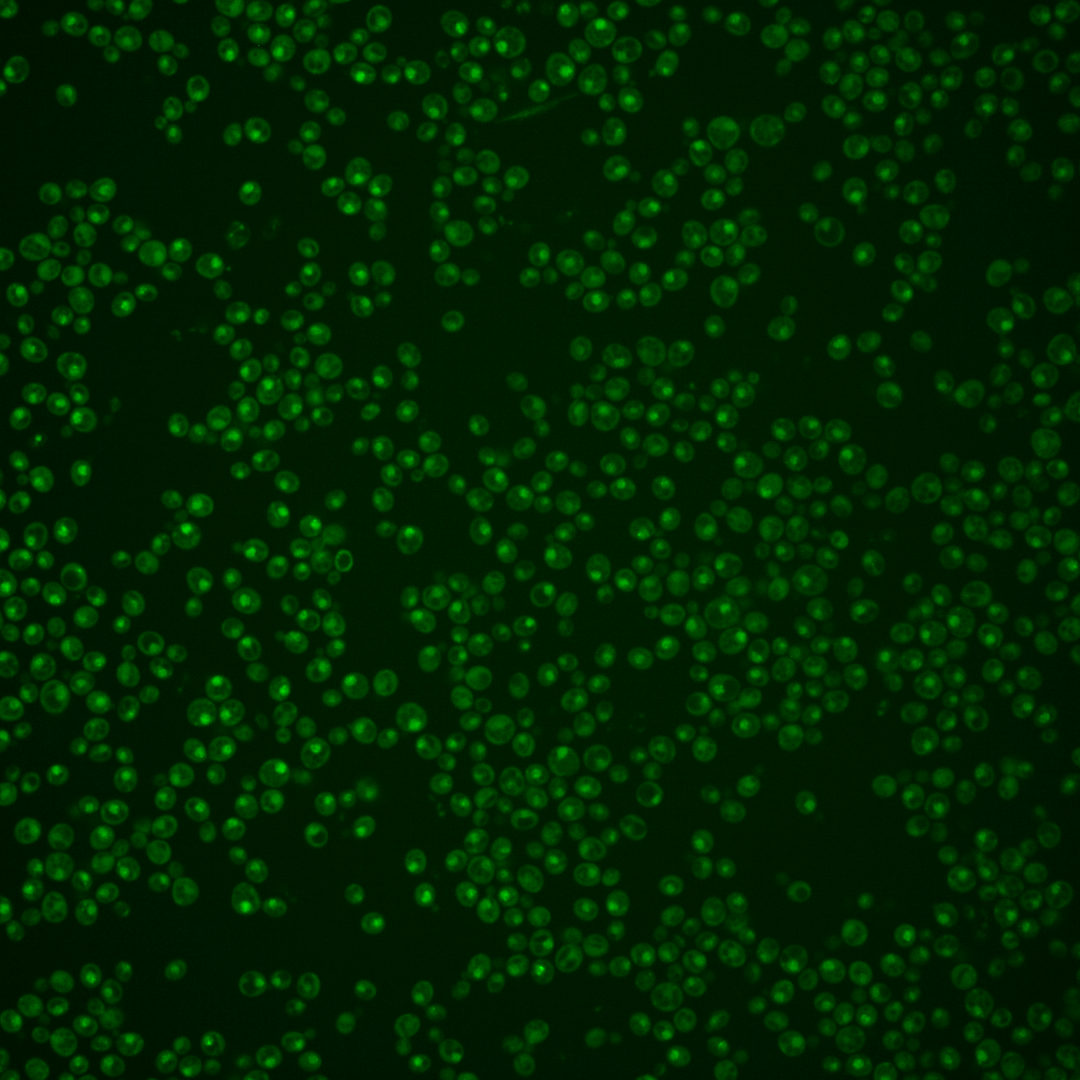
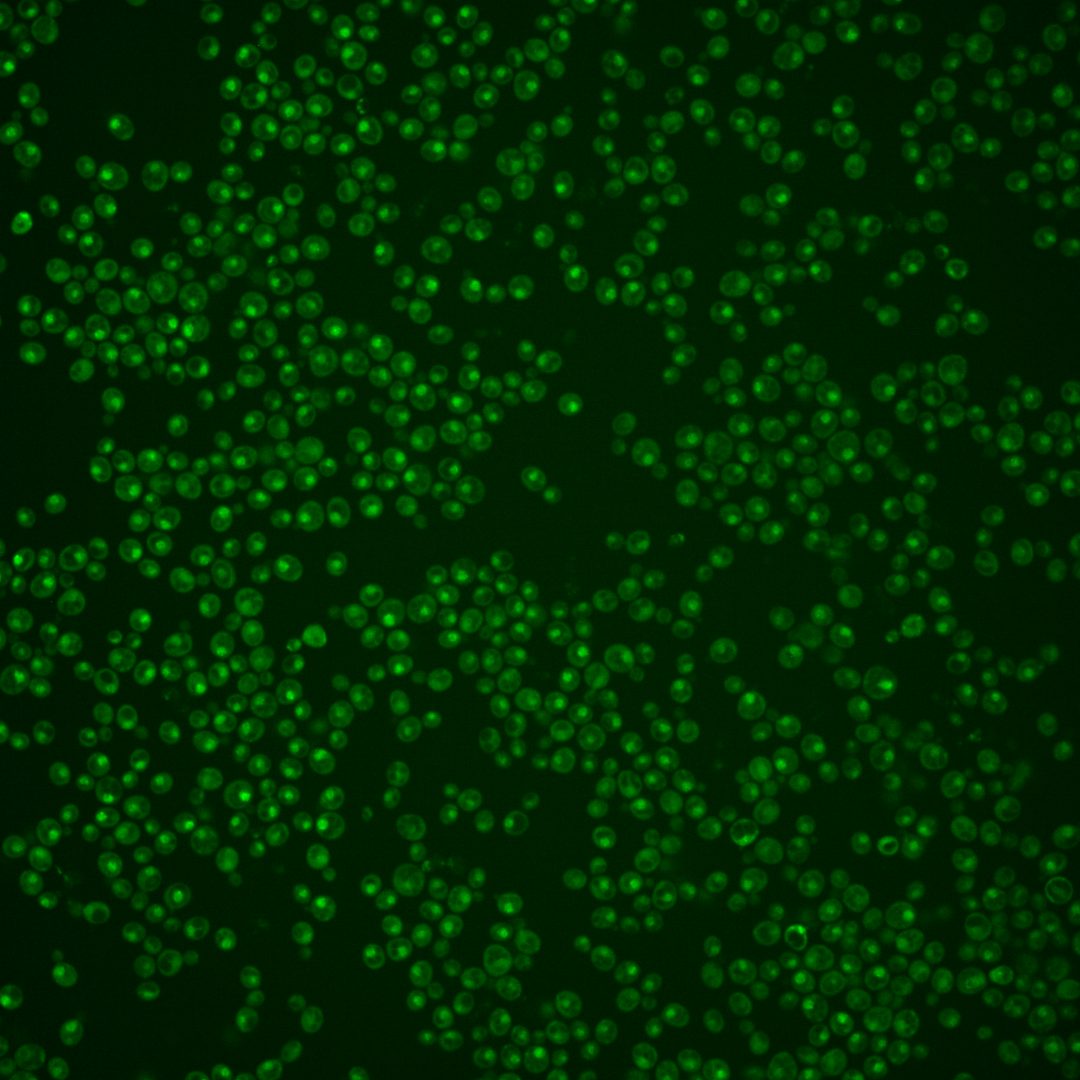

| Standard name | |
|---|---|
| Human Ortholog | |
| Description | DNA binding component of the SBF complex (Swi4p-Swi6p); a transcriptional activator that in concert with MBF (Mbp1-Swi6p) regulates late G1-specific transcription of targets including cyclins and genes required for DNA synthesis and repair; Slt2p-independent regulator of cold growth; acetylation at two sites, K1016 and K1066, regulates interaction with Swi6p |
Micrographs




















































































Sub-cellular Localization
Yeast GFP Assignment
Protein Abundance
Localization Change
External localization resources
| ensLOC | DeepLoc | |||||||||||||||||||||||
|---|---|---|---|---|---|---|---|---|---|---|---|---|---|---|---|---|---|---|---|---|---|---|---|---|
| Localization | WT1 | WT2 | WT3 | RAP60 | RAP140 | RAP220 | RAP300 | RAP380 | RAP460 | RAP540 | RAP620 | RAP700 | HU80 | HU120 | HU160 | rpd3Δ_1 | rpd3Δ_2 | rpd3Δ_3 | WT1 | WT2 | WT3 | AF100 | AF140 | AF180 |
| Cortical Patches | 0 | 0 | 0 | 0 | 0 | 0 | 0 | 0 | 0 | – | 0 | 0 | 0 | 0 | 0 | 0 | – | – | 0 | 0 | 0 | 0 | 0 | 1 |
| Bud | 0 | 0 | 0 | 0 | 3 | 1 | 4 | 12 | 8 | – | 9 | 9 | 0 | 0 | 0 | 0 | – | – | 1 | 8 | 4 | 1 | 4 | 2 |
| Bud Neck | 0 | 0 | 0 | 1 | 0 | 1 | 2 | 3 | 1 | – | 1 | 1 | 0 | 0 | 0 | 0 | – | – | 0 | 1 | 1 | 2 | 1 | 3 |
| Bud Site | 0 | 0 | 0 | 0 | 2 | 9 | 9 | 13 | 14 | – | 15 | 13 | 0 | 0 | 0 | 0 | – | – | – | – | – | – | – | – |
| Cell Periphery | 0 | 0 | 0 | 0 | 0 | 0 | 0 | 0 | 0 | – | 0 | 0 | 0 | 0 | 0 | 0 | – | – | 0 | 0 | 0 | 0 | 0 | 0 |
| Cytoplasm | 33 | 37 | 45 | 29 | 50 | 44 | 48 | 62 | 30 | – | 24 | 19 | 24 | 49 | 59 | 1 | – | – | 26 | 20 | 22 | 6 | 7 | 7 |
| Endoplasmic Reticulum | 0 | 4 | 1 | 0 | 0 | 0 | 0 | 1 | 0 | – | 0 | 0 | 0 | 0 | 2 | 0 | – | – | 0 | 0 | 1 | 0 | 0 | 1 |
| Endosome | 9 | 7 | 4 | 1 | 10 | 2 | 4 | 4 | 1 | – | 1 | 0 | 3 | 6 | 2 | 1 | – | – | 11 | 15 | 19 | 5 | 17 | 19 |
| Golgi | 0 | 1 | 0 | 0 | 0 | 0 | 0 | 0 | 0 | – | 0 | 0 | 0 | 0 | 0 | 0 | – | – | 0 | 5 | 3 | 1 | 1 | 0 |
| Mitochondria | 3 | 40 | 92 | 93 | 67 | 150 | 226 | 325 | 243 | – | 254 | 289 | 13 | 17 | 49 | 1 | – | – | 7 | 6 | 13 | 2 | 7 | 14 |
| Nucleus | 112 | 195 | 145 | 124 | 163 | 196 | 268 | 305 | 181 | – | 187 | 188 | 152 | 133 | 130 | 14 | – | – | 93 | 178 | 122 | 95 | 92 | 59 |
| Nuclear Periphery | 0 | 0 | 1 | 1 | 2 | 0 | 7 | 8 | 2 | – | 6 | 8 | 1 | 0 | 1 | 0 | – | – | 2 | 3 | 2 | 0 | 2 | 2 |
| Nucleolus | 6 | 8 | 4 | 5 | 13 | 32 | 46 | 78 | 64 | – | 56 | 66 | 11 | 5 | 12 | 1 | – | – | 27 | 34 | 34 | 26 | 26 | 30 |
| Peroxisomes | 0 | 0 | 0 | 0 | 0 | 0 | 0 | 0 | 0 | – | 0 | 0 | 0 | 0 | 0 | 0 | – | – | 0 | 0 | 0 | 0 | 0 | 0 |
| SpindlePole | 6 | 2 | 13 | 1 | 9 | 5 | 21 | 16 | 8 | – | 5 | 4 | 3 | 4 | 3 | 0 | – | – | 16 | 22 | 32 | 11 | 24 | 36 |
| Vac/Vac Membrane | 8 | 22 | 5 | 4 | 9 | 8 | 15 | 9 | 9 | – | 1 | 9 | 3 | 27 | 15 | 3 | – | – | 12 | 28 | 38 | 20 | 36 | 37 |
| Unique Cell Count | 168 | 282 | 252 | 206 | 276 | 333 | 474 | 586 | 372 | 359 | 403 | 191 | 225 | 243 | 21 | 207 | 328 | 305 | 175 | 229 | 227 | |||
| Labelled Cell Count | 177 | 316 | 310 | 259 | 328 | 448 | 650 | 836 | 561 | 559 | 606 | 210 | 241 | 273 | 21 | 207 | 328 | 305 | 175 | 229 | 227 | |||
Yeast GFP Assignment
Protein Abundance
| Screen | WT1 | WT2 | WT3 | RAP60 | RAP140 | RAP220 | RAP300 | RAP380 | RAP460 | RAP540 | RAP620 | RAP700 | HU80 | HU120 | HU160 | rpd3Δ_1 | rpd3Δ_2 | rpd3Δ_3 | AF100 | AF140 | AF180 |
|---|---|---|---|---|---|---|---|---|---|---|---|---|---|---|---|---|---|---|---|---|---|
| Mean Cell GFP Intensity (1e-4) | 5.5 | 4.7 | 4.1 | 3.8 | 4.6 | 4.2 | 4.1 | 3.9 | 3.5 | – | 3.6 | 3.6 | 5.1 | 4.7 | 4.1 | 7.4 | – | – | 4.7 | 4.7 | 5.4 |
| Std Deviation (1e-4) | 0.9 | 0.9 | 1.2 | 1.0 | 1.6 | 1.4 | 1.4 | 1.3 | 1.3 | – | 1.3 | 1.4 | 1.1 | 1.0 | 1.1 | 1.5 | – | – | 1.0 | 1.3 | 1.6 |
| Intensity Change (Log2) | – | – | – | -0.1 | 0.15 | 0.03 | -0.02 | -0.08 | -0.22 | – | -0.18 | -0.18 | 0.3 | 0.18 | 0.0 | 0.86 | – | – | 0.2 | 0.21 | 0.39 |
Localization Change
| Localization | RAP60 | RAP140 | RAP220 | RAP300 | RAP380 | RAP460 | RAP540 | RAP620 | RAP700 | HU80 | HU120 | HU160 | rpd3Δ_1 | rpd3Δ_2 | rpd3Δ_3 |
|---|---|---|---|---|---|---|---|---|---|---|---|---|---|---|---|
| Actin | – | – | – | – | – | – | – | – | – | – | – | – | – | – | – |
| Bud | – | – | – | – | – | – | – | – | – | – | – | – | – | – | – |
| Bud Neck | – | – | – | – | – | – | – | – | – | – | – | – | – | – | – |
| Bud Site | – | – | – | – | – | – | – | – | – | – | – | – | – | – | – |
| Cell Periphery | – | – | – | – | – | – | – | – | – | – | – | – | – | – | – |
| Cyto | – | – | – | – | – | – | – | – | – | – | – | – | – | – | – |
| Endoplasmic Reticulum | – | – | – | – | – | – | – | – | – | – | – | – | – | – | – |
| Endosome | – | – | – | – | – | – | – | – | – | – | – | – | – | – | – |
| Golgi | – | – | – | – | – | – | – | – | – | – | – | – | – | – | – |
| Mitochondria | – | – | – | – | – | – | – | – | – | – | – | – | – | – | – |
| Nuclear Periphery | – | – | – | – | – | – | – | – | – | – | – | – | – | – | – |
| Nuc | – | – | – | – | – | – | – | – | – | – | – | – | – | – | – |
| Nucleolus | – | – | – | – | – | – | – | – | – | – | – | – | – | – | – |
| Peroxisomes | – | – | – | – | – | – | – | – | – | – | – | – | – | – | – |
| SpindlePole | – | – | – | – | – | – | – | – | – | – | – | – | – | – | – |
| Vac | – | – | – | – | – | – | – | – | – | – | – | – | – | – | – |
| Cortical Patches | – | – | – | – | – | – | – | – | – | – | – | – | – | – | – |
| Cytoplasm | – | – | – | – | – | – | – | – | – | – | – | – | – | – | – |
| Nucleus | – | – | – | – | – | – | – | – | – | – | – | – | – | – | – |
| Vacuole | – | – | – | – | – | – | – | – | – | – | – | – | – | – | – |
External localization resources
Images






























Protein Concentration and Protein Localization Data
| R1 | R2 | R3 | ||||||||||||||||
|---|---|---|---|---|---|---|---|---|---|---|---|---|---|---|---|---|---|---|
| G1 Pre-START | G1 Post-START | S/G2 | Metaphase | Anaphase | Telophase | G1 Pre-START | G1 Post-START | S/G2 | Metaphase | Anaphase | Telophase | G1 Pre-START | G1 Post-START | S/G2 | Metaphase | Anaphase | Telophase | |
| Concentration | 2.5552 | 2.0938 | 2.0559 | 1.5495 | 2.0714 | 1.7767 | 3.3529 | 3.4752 | 3.4265 | 2.855 | 2.2869 | 2.9789 | 3.1336 | 4.5547 | 3.7388 | 3.7 | 3.1911 | 3.6144 |
| Actin | 0.0685 | 0.0004 | 0.0182 | 0.0045 | 0.0544 | 0.0023 | 0.0276 | 0.0014 | 0.0044 | 0.0045 | 0.0098 | 0.0056 | 0.0188 | 0.0009 | 0.0107 | 0.0306 | 0.0028 | 0.0006 |
| Bud | 0.0017 | 0.0022 | 0.0009 | 0.0133 | 0.0086 | 0.0004 | 0.0012 | 0.0044 | 0.0016 | 0.0157 | 0.031 | 0.0008 | 0.0007 | 0.0281 | 0.0011 | 0.0106 | 0.0476 | 0.0001 |
| Bud Neck | 0.0083 | 0.0012 | 0.0017 | 0.0236 | 0.008 | 0.0054 | 0.0056 | 0.0016 | 0.0011 | 0.0031 | 0.0081 | 0.0049 | 0.004 | 0.0015 | 0.0009 | 0.0032 | 0.0046 | 0.0015 |
| Bud Periphery | 0.0039 | 0.0022 | 0.0014 | 0.02 | 0.0128 | 0.0012 | 0.002 | 0.005 | 0.0024 | 0.0206 | 0.0408 | 0.0015 | 0.0022 | 0.0387 | 0.0015 | 0.0153 | 0.0622 | 0.0004 |
| Bud Site | 0.0053 | 0.0053 | 0.0095 | 0.01 | 0.0046 | 0.0005 | 0.0094 | 0.0082 | 0.0035 | 0.0052 | 0.0053 | 0.0006 | 0.0037 | 0.0394 | 0.001 | 0.0099 | 0.0043 | 0.0004 |
| Cell Periphery | 0.0006 | 0.0003 | 0.0003 | 0.0018 | 0.0009 | 0.0002 | 0.0006 | 0.0008 | 0.0008 | 0.0006 | 0.0009 | 0.0001 | 0.0004 | 0.0017 | 0.0001 | 0.0022 | 0.0012 | 0.0001 |
| Cytoplasm | 0.008 | 0.0129 | 0.0367 | 0.1983 | 0.3434 | 0.0233 | 0.0222 | 0.0311 | 0.0285 | 0.1734 | 0.271 | 0.0205 | 0.0068 | 0.081 | 0.0434 | 0.4209 | 0.418 | 0.0222 |
| Cytoplasmic Foci | 0.0092 | 0.0011 | 0.0042 | 0.016 | 0.0162 | 0.0017 | 0.0183 | 0.0008 | 0.0069 | 0.0153 | 0.0207 | 0.0027 | 0.0064 | 0.0018 | 0.0045 | 0.0146 | 0.0096 | 0.0047 |
| Eisosomes | 0.0006 | 0 | 0.0002 | 0.0003 | 0.0008 | 0 | 0.0003 | 0 | 0.0002 | 0.0002 | 0.0001 | 0 | 0.0002 | 0.0001 | 0 | 0.0012 | 0.0001 | 0 |
| Endoplasmic Reticulum | 0.0057 | 0.0026 | 0.0023 | 0.0165 | 0.0114 | 0.0007 | 0.0047 | 0.0011 | 0.0039 | 0.0085 | 0.0129 | 0.001 | 0.0011 | 0.0043 | 0.0017 | 0.0102 | 0.0083 | 0.0008 |
| Endosome | 0.023 | 0.0083 | 0.0087 | 0.0342 | 0.0267 | 0.0021 | 0.034 | 0.0007 | 0.0181 | 0.0271 | 0.0518 | 0.0061 | 0.0163 | 0.0015 | 0.0025 | 0.0102 | 0.0061 | 0.0088 |
| Golgi | 0.0085 | 0.0004 | 0.0043 | 0.0029 | 0.009 | 0.0005 | 0.0089 | 0.0001 | 0.0058 | 0.0022 | 0.0062 | 0.0025 | 0.0055 | 0.0002 | 0.0078 | 0.0064 | 0.0004 | 0.0007 |
| Lipid Particles | 0.0145 | 0.0005 | 0.0104 | 0.0336 | 0.0207 | 0.001 | 0.027 | 0.0002 | 0.0024 | 0.0044 | 0.0099 | 0.0061 | 0.0085 | 0.0003 | 0.0003 | 0.0276 | 0.0004 | 0.002 |
| Mitochondria | 0.0085 | 0.001 | 0.0114 | 0.0043 | 0.0233 | 0.0064 | 0.0116 | 0.0006 | 0.0112 | 0.013 | 0.0082 | 0.0061 | 0.0054 | 0.0012 | 0.0017 | 0.0162 | 0.0044 | 0.0089 |
| None | 0.0083 | 0.0107 | 0.0206 | 0.1983 | 0.0873 | 0.0046 | 0.0133 | 0.0125 | 0.0073 | 0.1293 | 0.1212 | 0.0202 | 0.0019 | 0.1582 | 0.0249 | 0.1733 | 0.1408 | 0.0031 |
| Nuclear Periphery | 0.0757 | 0.0187 | 0.0175 | 0.017 | 0.0307 | 0.0072 | 0.0373 | 0.0145 | 0.0108 | 0.0317 | 0.0357 | 0.0074 | 0.0137 | 0.0077 | 0.0109 | 0.0145 | 0.0088 | 0.0106 |
| Nucleolus | 0.0342 | 0.0422 | 0.019 | 0.0105 | 0.0171 | 0.0824 | 0.0367 | 0.0352 | 0.0167 | 0.0195 | 0.0129 | 0.0686 | 0.0464 | 0.011 | 0.0251 | 0.0063 | 0.0072 | 0.075 |
| Nucleus | 0.6538 | 0.8489 | 0.7814 | 0.3459 | 0.2182 | 0.8315 | 0.6931 | 0.8485 | 0.8557 | 0.4827 | 0.3029 | 0.8199 | 0.7928 | 0.6036 | 0.8347 | 0.1683 | 0.2399 | 0.8433 |
| Peroxisomes | 0.009 | 0.0001 | 0.0086 | 0.0019 | 0.0242 | 0.0006 | 0.0107 | 0.0001 | 0.0016 | 0.0016 | 0.0058 | 0.004 | 0.0104 | 0.0001 | 0.0126 | 0.0273 | 0.0004 | 0.0005 |
| Punctate Nuclear | 0.0427 | 0.033 | 0.0389 | 0.0213 | 0.057 | 0.0264 | 0.0292 | 0.0305 | 0.012 | 0.0254 | 0.0238 | 0.0193 | 0.05 | 0.0083 | 0.0126 | 0.0084 | 0.0066 | 0.0144 |
| Vacuole | 0.0059 | 0.0059 | 0.0023 | 0.0219 | 0.0193 | 0.0013 | 0.0043 | 0.0021 | 0.0039 | 0.0119 | 0.0157 | 0.0011 | 0.0037 | 0.0095 | 0.0015 | 0.0184 | 0.022 | 0.0011 |
| Vacuole Periphery | 0.0041 | 0.0019 | 0.0015 | 0.0037 | 0.0053 | 0.0004 | 0.0023 | 0.0004 | 0.0013 | 0.004 | 0.0054 | 0.0007 | 0.0012 | 0.001 | 0.0005 | 0.0044 | 0.0044 | 0.0008 |
Sequencing Data
| R1 | R2 | |||||||||
|---|---|---|---|---|---|---|---|---|---|---|
| G1 Post-START | S/G2 | Metaphase | Anaphase | Telophase | G1 Post-START | S/G2 | Metaphase | Anaphase | Telophase | |
| Gene Expression | 26.7278 | 4.2076 | 8.4746 | 32.9984 | 21.7948 | 17.1366 | 10.1039 | 8.7166 | 18.7353 | 35.1224 |
| Translational Efficiency | 0.9965 | 0.9506 | 1.0196 | 0.4602 | 0.876 | 2.0135 | 0.6129 | 0.7268 | 0.7634 | 0.7474 |
Hit Data
| Dataset | Hit |
|---|---|
| Protein Concentration | ✘ |
| Protein Localization | ✔ |
| Gene Expression | ✔ |
| Translational Efficiency | ✘ |
Endocytosis
| Temp | Actin Patch (Sac6-tdTomato) | Cortical Patch (Sla1-GFP) | Late Endosome (Snf7-GFP) | Vacuole (Vph1-GFP) |
|---|---|---|---|---|
| 37℃ | ||||
| RT |
Cell Cycle Omics
CYCLoPs (Swi4-GFP)
| Gene / Allele | Actin Patch (Sac6-tdTomato) | Cortical Patch (Sla1-GFP) | Late Endosome (Snf7-GFP) | Vacuole (Sac6-tdTomato) |
|---|
| Gene | Images |
|---|
| Gene | Images |
|---|
Images are not yet available
Images are not yet available